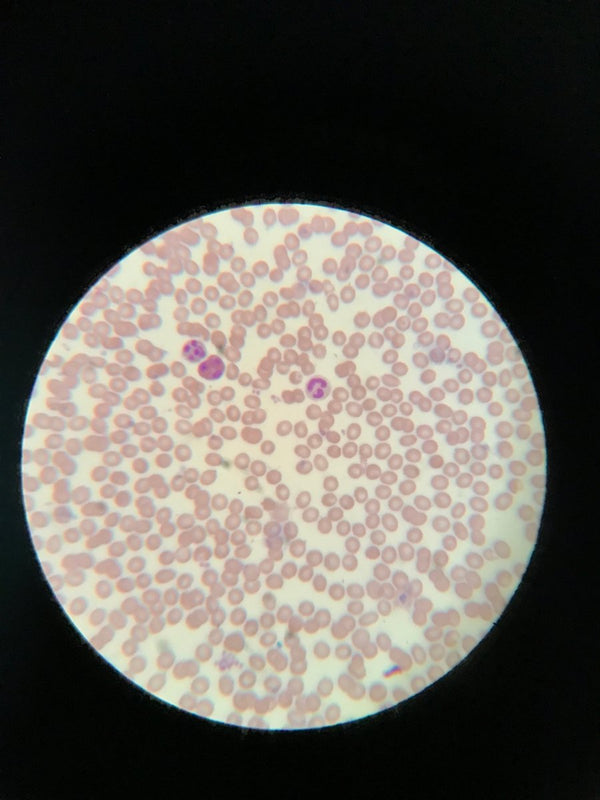
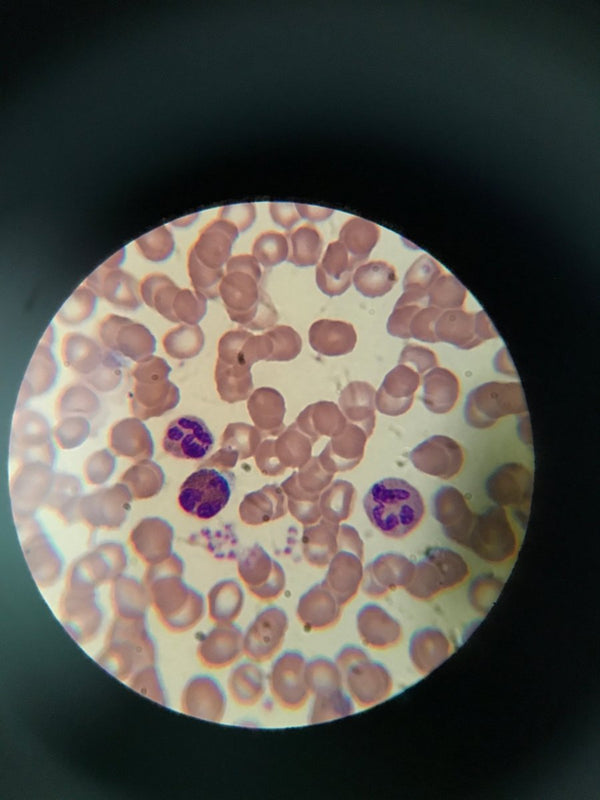
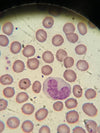

Wright's Blood Stain Kit with Bibulous Paper
- Sale price
- $10 USD
- List price
- $12.15 USD
Wright's Blood Stain and Phosphate Buffer in 1 convenient package. Wright's stain is used in histology to differentiate blood cells. Composed of a mixture of red and blue dyes, it is used primarily to stain peripheral blood smears and bone marrow aspirates which are examined under a microscope. Phosphate Buffer is used in conjunction with Wright's stain in the staining and rinsing process. Basic instructions are included. Methods and preferences vary, therefore, we recommended you research options for your application and choose the method best for you. Available in 2 sizes. SKU BZ1250, BZ1250L
- A Red/Blue Histologic Stain that Differentiates Blood Cells
- Small Kit contains 15 ml Wright's Blood Stain and 30ml Buffer (BZ1250)
- Large Kit contains 120ml Wright's Blood Stain and 250ml Buffer (BZ1250L)
- Bibulous Paper 50ct, 4" x 6"
- Includes Basic Instructions
- Safety Data Sheets
- For educational laboratory use only. Keep out of reach of children.
DOT Info: Small quantity exemption for land and rail transportation only. (Cannot ship to Hawaii, PR, APO or FPO.)
Everything was great with this item
It left lots of stain artifacts and platelets in perpetual blood didn’t really take up the stain, but it was fine enough since I wasn’t expecting too much from it.
Amazon Rating
Amazon Rating
Hi, Just to let you know that we have just received the item, Today Monday January 30. Thanks, Gina